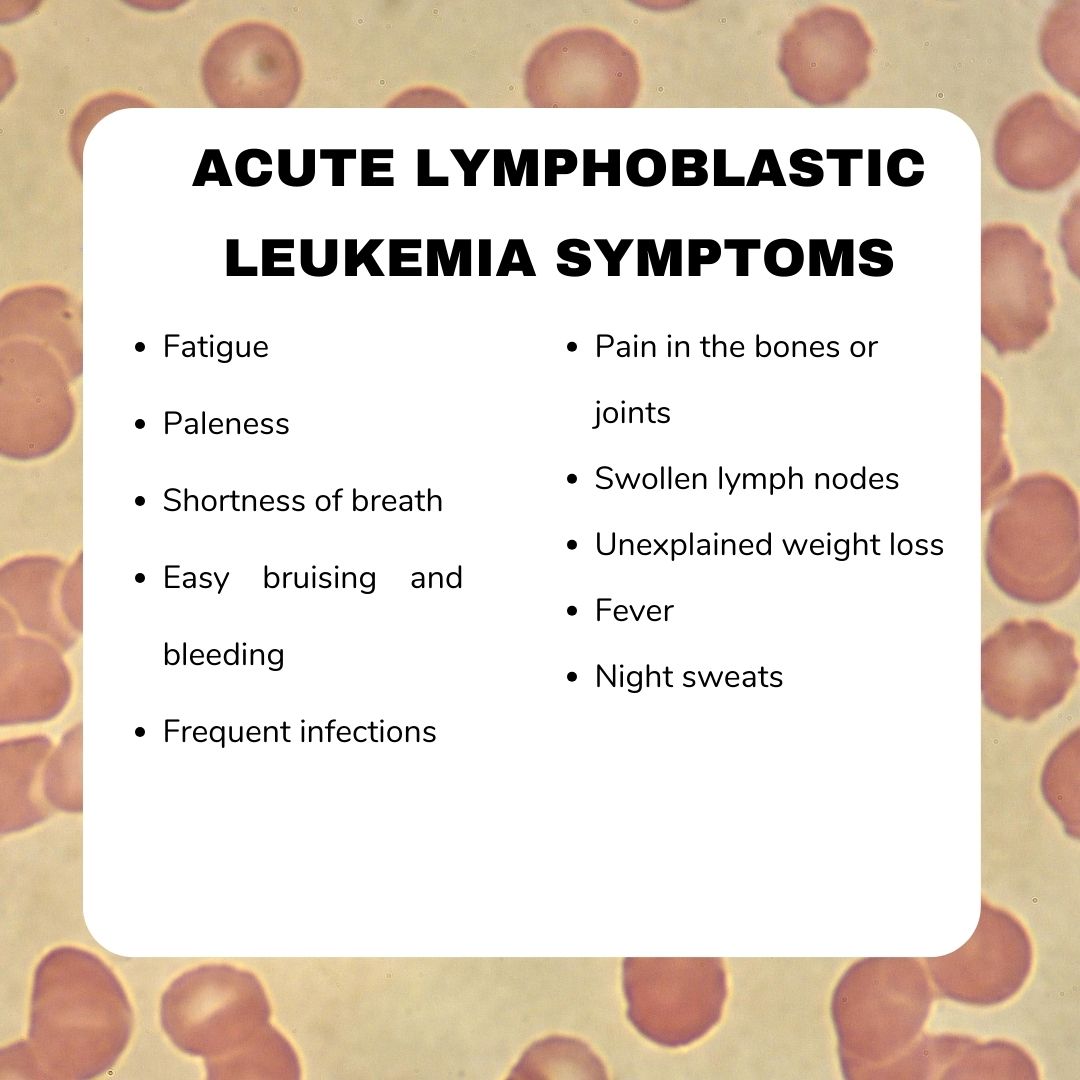

Acute Lymphoblastic Leukemia (ALL) is the most common type of cancer in children, but thanks to advances in treatment, the majority of children with ALL can be cured. For parents and caregivers, understanding the disease, its treatment, and how to support a child through this journey is essential.

What is Acute Lymphoblastic Leukemia (ALL)?
Acute Lymphoblastic Leukemia (ALL) is a type of cancer that affects the blood and bone marrow—the part of the body that makes blood cells. In ALL, the body starts making too many immature white blood cells, called lymphoblasts. These abnormal cells don’t work properly and begin to crowd out the healthy cells that the body needs to fight infections, carry oxygen, and stop bleeding.
Because of this, children with ALL may feel very tired, get frequent infections, or bruise and bleed easily. It’s called “acute” because it can develop quickly and needs prompt treatment—but with the right care, most children respond very well.
Types of Acute Lymphoblastic Leukemia (ALL)
Although all cases of ALL involve the overproduction of immature white blood cells (called lymphoblasts), not all ALL is the same. There are different subtypes, and knowing which type a person has helps doctors choose the most appropriate treatment plan.
ALL is mainly classified based on which type of lymphocyte (a kind of white blood cell) has become cancerous and the genetic features of the leukemia cells. The two main types of ALL are:
- B-cell ALL: This is the most common form, especially in children. It begins in early forms of B lymphocytes, which normally help the body fight infections. B-cell ALL tends to respond very well to standard treatments, and the prognosis is often excellent. Even within B-cell ALL, there are further subtypes based on genetic markers, such as Philadelphia chromosome-positive (Ph+) ALL or hyperdiploid ALL, which can influence treatment decisions.
- T-cell ALL: This type starts in T lymphocytes, another type of white blood cell that plays a role in the immune system. T-cell ALL is less common than B-cell ALL but is more likely to occur in older children, teenagers, and adults. It may sometimes cause a mass in the chest, leading to breathing difficulties. T-cell ALL often requires a slightly different treatment approach but still has good outcomes when treated appropriately.
In addition to identifying whether the leukemia is B-cell or T-cell, doctors also look closely at the genetic characteristicsof the leukemia cells. Specific genetic changes—such as translocations, deletions, or extra chromosomes—can help predict how the leukemia will behave and how it is likely to respond to treatment. Knowing the type and genetic profile of ALL is an important part of making an accurate diagnosis and creating a personalized treatment plan. These tests are done using specialized techniques in the lab and help doctors offer the best care based on each patient’s unique situation.

Causes and Risk Factors of ALL
One of the most difficult questions people ask after a diagnosis of acute lymphoblastic leukemia (ALL) is: “Why did this happen?” It’s a natural response—but in most cases, the exact cause of ALL is not fully understood.
Unlike some other cancers, ALL does not have a single known cause. It usually develops because of random genetic changes in immature white blood cells (lymphoblasts) in the bone marrow. These changes happen by chance, not because of anything the patient or their family did or didn’t do. However, researchers have identified some risk factors—conditions or exposures that may increase the likelihood of developing ALL. It’s important to remember that having a risk factor does not mean someone will definitely develop leukemia, and most people with ALL have no known risk factors at all. Here are some of the known or suspected risk factors: Some inherited genetic conditions can slightly increase the risk of developing ALL. These include:
- Down syndrome
- Li-Fraumeni syndrome
- Neurofibromatosis type 1 (NF1)
- Fanconi anemia
- Bloom syndrome
While the overall risk remains low, children with these conditions are more closely monitored for signs of leukemia. Exposure to high levels of ionizing radiation, such as from radiation therapy or atomic bomb exposure, has been linked to a higher risk of leukemia. However, routine medical imaging (like X-rays) uses very low doses and is not considered a significant risk. People who have received certain types of chemotherapy or radiation therapy to treat a different cancer may have a slightly increased risk of developing ALL later on. This is called therapy-related leukemia, and it is more common in adults than in children. Some studies have explored possible links between ALL and exposure to certain chemicals (like benzene), pesticides, or industrial pollutants. However, results are mixed, and no direct cause-and-effect has been confirmed. Having a close relative (especially a sibling) with ALL slightly increases the risk, though the overall risk remains very low. ALL is not contagious and does not spread from person to person.
Symptoms of Acute Lymphoblastic Leukemia
The early symptoms of acute lymphoblastic leukemia (ALL) can be quite general and often resemble those of common childhood illnesses, such as viral infections. However, recognizing these signs early is important, as timely diagnosis and treatment can significantly improve outcomes.
One of the most common early signs is fever, often without a clear cause. Children with ALL may also experience frequent or severe infections because the leukemia affects the body’s ability to fight off germs. Another frequent symptom is easy bruising or bleeding, such as nosebleeds, bleeding gums, or small red or purple spots on the skin (petechiae). These occur due to a low platelet count, which affects the blood’s ability to clot. Bone and joint pain is also a common feature, caused by the bone marrow becoming crowded with abnormal leukemia cells. Some children may limp, avoid movement, or complain of pain in their legs, arms, or back. As leukemia progresses, the production of healthy red blood cells is reduced, leading to anemia, which may cause fatigue, pale skin (pallor), and shortness of breath.
Swelling in the abdomen may be noticed as well, often due to enlargement of the liver or spleen. This can cause abdominal discomfort, pain, or a feeling of fullness even after eating little. Additionally, swollen lymph nodes—especially in the neck, armpits, groin, or abdomen—may be noticeable due to the buildup of leukemia cells in these areas. In some types of ALL, particularly T-cell ALL, leukemia cells may form a mass in the chest area, potentially pressing on the airways and causing difficulty breathing or chest pain. In rare cases, leukemia can spread to the central nervous system, leading to persistent headaches, vomiting, blurred vision, or changes in behavior. Unexplained weight lossor a general decline in well-being may also be early warning signs.
It’s important to remember that these symptoms are not specific to leukemia and can occur in many other childhood conditions. However, when symptoms are persistent, unusual, or worsening, they should be evaluated by a healthcare professional to ensure accurate diagnosis and prompt care.
How Is ALL Diagnosed
When a child shows symptoms that might suggest leukemia, the first step is usually a blood test. This simple test can show if there are too many white blood cells or not enough red blood cells or platelets—an early clue that something may be wrong.
If the results are concerning, your child’s doctor may refer you to a specialist for further testing. The next step is often a bone marrow test, called a bone marrow biopsy or aspiration. This involves taking a small sample of the soft tissue inside the bone (usually from the back of the hip) to check for leukemia cells. Although this test may sound scary, it’s done under local anesthesia or sedation, so your child won’t feel pain during the procedure. In some cases, a lumbar puncture (spinal tap) is also done. This helps doctors see whether the leukemia has spread to the fluid around the brain and spinal cord. This test is also done gently and safely, often under sedation to keep your child calm and comfortable.
Another important part of diagnosis is genetic testing on the leukemia cells. These tests look at specific changes in the DNA of the cancer cells. They help doctors understand the type and behavior of the leukemia, which is important for choosing the most effective treatment plan for your child. Doctors may also do imaging tests (like an ultrasound or chest X-ray) to check for swelling in organs like the liver, spleen, or lymph nodes.
Treatment Options
Treatment for acute lymphoblastic leukemia (ALL) is a carefully structured process that takes place over several phases. Although the overall duration typically spans two to three years, most of the more intensive treatment occurs during the first several months. The goal is not only to eliminate the leukemia cells but also to prevent the disease from coming back.
-
Induction Therapy – The first step is called induction therapy, and it begins as soon as the diagnosis is confirmed. This phase usually lasts around 4 to 6 weeks and is designed to rapidly destroy as many leukemia cells as possible. It often involves a combination of chemotherapy drugs, administered in different ways—by mouth, through a vein, or directly into the spinal fluid to reach the brain and spinal cord. Doctors monitor the body’s response closely, and by the end of this phase, most patients enter what’s called remission, meaning there are no visible signs of leukemia in the blood or bone marrow.
-
Consolidation (or Intensification) – Even after remission is achieved, some leukemia cells may still be present, hiding in the body. The next phase, known as consolidation or intensification, is designed to target and eliminate any remaining cancer cells to reduce the risk of relapse. This phase usually lasts for a few months and involves more chemotherapy—often using stronger or different drug combinations. In some cases, targeted therapy may also be added, depending on the specific genetic features of the leukemia.
-
Maintenance Therapy – Once the leukemia has been pushed into remission and the remaining cancer cells have been addressed, treatment enters a longer but less intensive phase called maintenance therapy. This stage can last 1 to 2 years and helps ensure the leukemia does not return. Chemotherapy is typically given at lower doses, often as oral medications taken at home, with regular check-ups at the clinic. Most patients feel better during this time and are able to return to many of their usual activities.
-
Additional Therapies – In some cases, especially when the leukemia does not respond well to initial treatment or returns later, additional options may be considered. These can include: Targeted therapies, which are newer treatments that focus on specific abnormalities n leukemia cells. A stem cell (bone marrow) transplant, which replaces damaged bone marrow with healthy cells from a donor. This is usually reserved for high-risk cases or when other treatments have not been fully successful.
Each treatment plan is carefully tailored based on the patient’s age, overall health, genetic test results, and how the leukemia responds to therapy. While the journey may seem long, many people complete treatment successfully and go on to live healthy, fulfilling lives.
Side Effects and Support
During treatment for acute lymphoblastic leukemia (ALL), it’s common to experience a range of side effects. These can vary depending on the type and intensity of therapy, but many people report feeling fatigued, nauseated, or experiencing hair loss. Because chemotherapy affects the immune system, there is also an increased risk of infections, so staying vigilant and reporting any signs of fever or illness is important.
Some side effects may be temporary and manageable, while others may require medication or supportive care. It’s essential to communicate openly with the healthcare team about any physical symptoms or changes, no matter how small they may seem. Beyond the physical challenges, treatment can also affect emotional and mental well-being. Feelings of anxiety, sadness, or frustration are completely normal. Emotional support—from loved ones, mental health professionals, or support groups—can play a vital role in coping throughout the treatment process.
Maintaining good nutrition is also an important part of care. Appetite changes are common, but balanced meals, hydration, and guidance from a dietitian can help the body tolerate treatment better and support recovery. For children and adolescents, keeping up with school, friendships, and daily routines as much as possible can provide a sense of normalcy and stability. Schools and teachers can often make accommodations to support learning during treatment. Throughout this journey, no one should feel alone. Patients and caregivers are encouraged to ask questions, seek guidance, and make use of available psychosocial support services, such as counseling, social workers, and patient navigators. These services can ease the emotional and practical burdens of treatment and help everyone involved feel more supported and informed.
Prognosis for Acute Lymphoblastic Leukemia (ALL)
Thanks to decades of progress in medical research and treatment, the prognosis for acute lymphoblastic leukemia (ALL) has improved dramatically—especially in children and young people. Today, most people diagnosed with ALL can be treated successfully, and many go on to live full, healthy lives after treatment.
In children, especially those between the ages of 1 and 10 with standard-risk disease, long-term survival rates are very high—around 85–90% or more in developed countries. For adolescents and adults, outcomes have also improved, though survival rates can be lower than in younger children. The exact prognosis depends on a number of factors, including:
- Age at diagnosis
- White blood cell count at the time of diagnosis
- Whether the leukemia is B-cell or T-cell type
- How well the leukemia responds to early treatment
- Certain genetic features of the leukemia cells
- Whether the disease is newly diagnosed or has relapsed
One of the most important milestones during treatment is achieving remission, which means there are no visible signs of leukemia in the blood or bone marrow. Most patients reach remission within the first few weeks of treatment. It’s important to remember that even after remission is achieved, continued treatment is needed to prevent relapse. Regular follow-up care, blood tests, and bone marrow exams help ensure that if any leukemia cells return, they can be detected and treated early.
In cases where the leukemia does come back (relapse), there are still treatment options available, including more intensive chemotherapy, targeted therapies, or stem cell transplantation, depending on individual circumstances. While every person’s journey is unique, the outlook for ALL is now more hopeful than ever before. Ongoing support from healthcare teams, advances in personalized medicine, and strong emotional and social support all play a role in achieving the best possible outcome.
Common Myths About Acute Lymphoblastic Leukemia (ALL)
There are many myths and misconceptions about ALL that can cause confusion or fear. Understanding the facts can help patients and caregivers feel more confident and informed throughout the treatment journey.
- Leukemia is always fatal: This is no longer true. With modern treatments, most children—and many adults—with ALL achieve long-term remission or are cured. Survival rates for childhood ALL now exceed 85–90% in many countries.
- Leukemia is contagious: Leukemia is not infectious. It cannot be spread from one person to another through touch, air, food, or water.
- It’s caused by something the patient or family did: ALL is usually caused by random genetic mutations in developing blood cells. It is not linked to lifestyle, parenting, or anything that could have been prevented.
- Natural remedies or special diets can cure leukemia: While good nutrition supports overall health, ALL requires medical treatment, such as chemotherapy or targeted therapy. Relying on unproven alternatives instead of medical care can be harmful.
- People with leukemia can’t return to normal life: Many people who are treated for ALL go on to live full, active lives. With proper care and support, children often return to school, and adults resume work and daily activities after treatment.
You Can Watch More on OncoDaily Youtube TV
FAQ
What is Acute Lymphoblastic Leukemia (ALL)?
ALL is a type of cancer that affects the blood and bone marrow by producing too many immature white blood cells (lymphoblasts), which interfere with normal blood cell function.
What are the main types of ALL?
The two main types are B-cell ALL (most common in children) and T-cell ALL (more common in teens and adults), each requiring different treatment approaches.
What causes ALL?
The exact cause is usually unknown. Most cases result from random genetic mutations. Some risk factors include genetic syndromes (like Down syndrome), prior radiation, or family history.
What are the symptoms of ALL in children?
Common signs include persistent fever, frequent infections, easy bruising or bleeding, bone pain, swollen lymph nodes, fatigue, and pale skin.
How is ALL diagnosed?
Diagnosis involves blood tests, bone marrow biopsy, genetic testing of leukemia cells, and sometimes spinal fluid testing or imaging to check for spread.
What are the common side effects of treatment?
Side effects include fatigue, nausea, hair loss, increased infection risk, and emotional stress. Supportive care and open communication with the care team are essential.
What is the prognosis for children with ALL?
With current treatments, 85–90% of children with ALL can be cured, especially those aged 1–10 with standard-risk disease.
Can children with ALL return to normal life?
Yes, many children return to school, play, and other normal activities during and after treatment, especially during maintenance therapy.
Is leukemia contagious or caused by something preventable?
No. ALL is not contagious and is not caused by parenting, diet, or lifestyle choices. It results from random mutations in blood cell development.